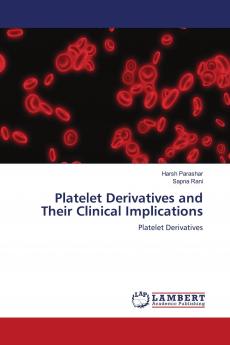
Platelet Derivatives and Their Clinical Implications

English
Paperback
₹5070
₹5337
5% OFF
(All inclusive*)
Delivery Options
Please enter pincode to check delivery time.
*COD & Shipping Charges may apply on certain items.
Review final details at checkout.
Looking to place a bulk order? SUBMIT DETAILS
Delivery Options
Please enter pincode to check delivery time.
*COD & Shipping Charges may apply on certain items.
Review final details at checkout.
About The Book
Description
Author
Platelet rich blood derivatives have been widely used in different fields of medicine and stem cell based tissue engineering. They have consistently shown to potentiate stem cell proliferation migration and differentiation. During natural wound healing activated platelets concentrate in the wound area and secrete a plethora of factors that play an instrumental role in coordinating wound healing. Activation of platelet triggers degranulation and subsequent release of trophic factors that influence wound healing tissue repair angiogenesis and stem cell behavior. The PRF and plasma have emerged as a powerful therapeutic tool for management of soft and hard tissue healing and regenerative procedures including implant osseointegration. The in vivo and in vitro results have opened a new avenue in the dentistry and medicinal care. This minimal invasive and cost-effective technique will raise the bar of clinical dentistry practiced at present.
Details
ISBN 13
9786200095596
Publication Date
-20-04-2022
Pages
-92
Weight
-131 grams
Dimensions
-150x220x5.33 mm